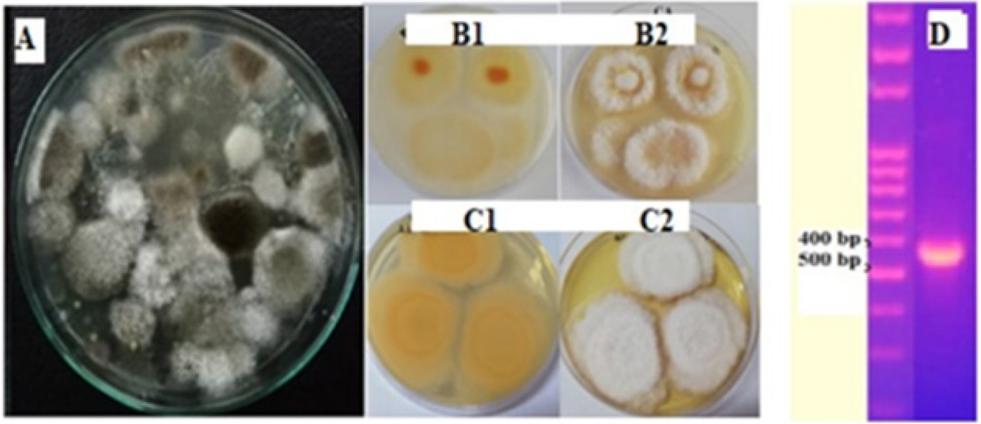

Figure 1
Figure 2

Figure 3

Figure 4

Figure 5

Genotoxic evaluation of AgNO3 and AgNPs using SMART assay
| Treatments | Number of Wings (N) | Small uniform clones (1-2 cells) (m=2) | Large uniform clones (> 2 cells) (m=5) | Twin clones (m=5) | Total mwh clones (m=2) | Total clones (m=2) | ||||||||||
|---|---|---|---|---|---|---|---|---|---|---|---|---|---|---|---|---|
| No. | Fr. | D. | No. | Fr. | D. | No. | Fr. | D. | No. | Fr. | D. | No. | Fr. | D. | ||
| Normal Wing | ||||||||||||||||
| Distilled Water | 80 | 12 | (0.16) | 2 | (0.02) | 0 | (0.00) | 13 | (0.19) | 14 | (0.19) | 0.76 | ||||
| 1 EMS mM | 31 | 69 | (2.21) | + | 27 | (0.83) | + | 9 | (0.27) | + | 105 | (3.31) | + | 104 | (3.40) | + 5.38 |
| AgNO3 (ppm) | ||||||||||||||||
| 0.1 | 80 | 15 | (0.16) | i | 5 | (0.06) | i | 0 | (0.00) | i | 20 | (0.25) | i | 20 | (0.25) | i 1.02 |
| 1 | 80 | 9 | (0.07) | - | 2 | (0.02) | i | 0 | (0.00) | - | 8 | (0.10) | - | 1 | (0.10) | - 0.41 |
| 10 | 80 | 5 | (0.01) | - | 2 | (0.02) | i | 0 | (0.00) | - | 3 | (0.03) | - | 7 | (0.03) | - 0.15 |
| AgNPs (ppm) | ||||||||||||||||
| 0.1 | 80 | 15 | (0.16) | i | 5 | (0.06) | i | 0 | (0.00) | i | 20 | (0.25) | i | 20 | (0.25) | i 1.02 |
| 1 | 80 | 6 | (0.05) | - | 2 | (0.02) | i | 0 | (0.00) | - | 8 | (0.8) | - | 8 | (0.8) | - 0.39 |
| 10 | 80 | 4 | (0.01) | - | 2 | (0.02) | i | 0 | (0.00) | - | 3 | (0.03) | - | 6 | (0.03) | - 0.15 |
Antimicrobial activity of CFF, AgNO3, and AgNPs_
| Agents | Diameter zone (mm) ± Standard Deviation | ||||
|---|---|---|---|---|---|
| S. aureus ATCC 25923 | P. aeruginosa ATCC 27853 | E. coli ATCCC 25922 | B. subtilis | ||
| Vancomycin (30 μg) | 21±2 | 8.67±0.58 | 25±1 | 2±1.73 | |
| Penicillin (10 μg) | 41±3 | Not determined | 33.67±0.58 | 30.67±2.08 | |
| Chloramphenicol (30 μg) | 26.67±0.58 | 16±1.73 | 30.33±1.53 | 36±1.73 | |
| Erythromycin (15 μg) | 30.33±2.08 | 9±1 | 26.67±1.53 | 29±1 | |
| Tetracycline (30 μg) | 30.33±2.52 | 14.67±0.58 | 11.67±0.58 | 16±2 | |
| Cell-Free Filtrate | 0 | 0 | 0 | 0 | |
| Ag NO3 2,5 mM | 18.33±1.53 | 13±1 | 14.33±1.15 | 16.33±1.53 | |
| AgNPs | 10 ppm | 10±1.73 | 12.33±1.53 | 12.33±1.53 | 17± 1 |
| 1 ppm | 9±1 | 1±1.73 | 0 | 16.33± 2.08 | |
| 0.1 ppm | 0 | 0 | 0 | 8.33±0.58 | |
Biofilm inhibition (%) of AgNPs against P_ aeruginosa ATCC 27853
| AgNPs | |||
|---|---|---|---|
| Inhibition % (n=3) | 10 ppm | 1 ppm | 0.1 ppm |
| 81.13 | 67.63 | 40.28 | |
| 76.25 | 65.45 | 45.11 | |
| 80.62 | 63.32 | 40.43 | |
| Average biofilm inhibition (%) ± Standard Deviation | 79.33±2.68 | 65.47±2.16 | 41.94±2.75 |